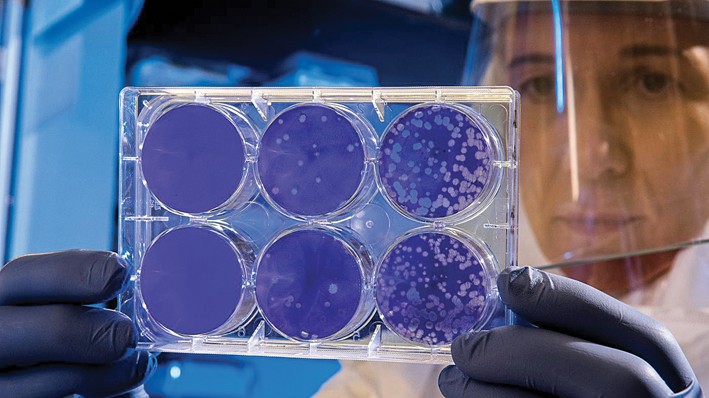

Impennata del Coronavirus
Il Saviglianese è anche su Whatsapp. Clicca qui per iscriverti gratuitamente al canale ed essere sempre aggiornato sulle ultime novità.
MARENE Sono saliti a 19 i casi dei marenesi attualmente positivi al Covid. Un’impennata dovuta anche ad un numeroso nucleo familiare coinvolto. Tutti i particolari sul numero in edicola.
